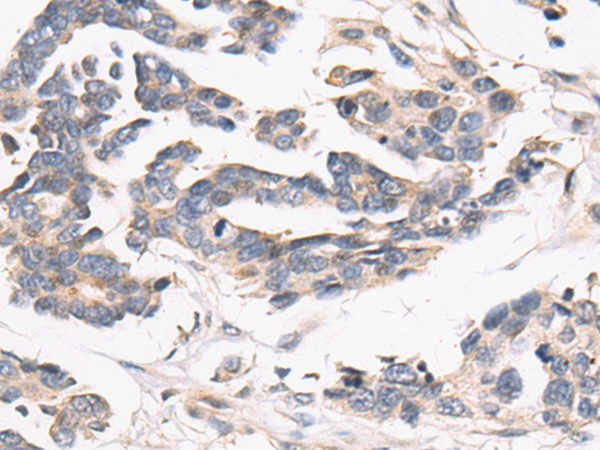
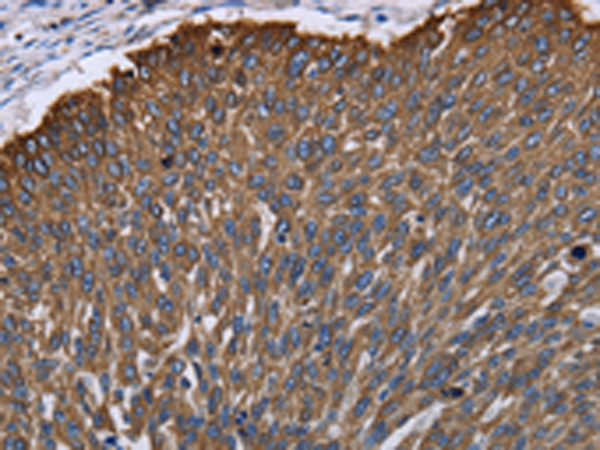
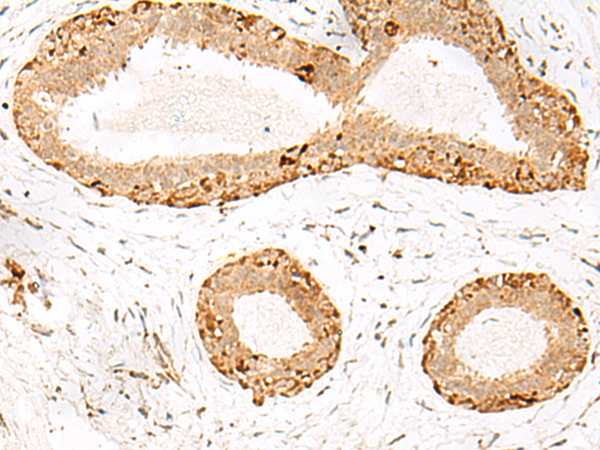
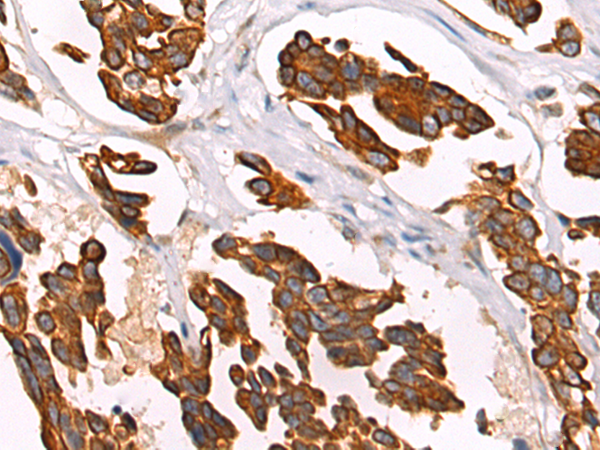

-
分类: 科研抗体货号: P00225别名: CMH7; RCM1; cTnI; CMD2A; TNNC1; CMD1FF应用: WB,IHC反应种属: Human, Mouse, Rat
-
分类: 科研抗体货号: P00172别名: K23; CK23; HAIK1应用: WB,IHC反应种属: Human, Mouse
-
分类: 科研抗体货号: P00260别名: KIP1; MEN4; CDKN4; MEN1B; P27KIP1应用: IHC反应种属: Human, Mouse
-
分类: 科研抗体货号: P00218别名: CANPX; CAPNX; CalpM; DJ914P14.1应用: WB,IHC反应种属: Human, Mouse, Rat
-
分类: 科研抗体货号: P00171别名: HA1, Ha-1, hHa1, KRTHA1应用: WB,IHC反应种属: Human, Mouse
-
分类: 科研抗体货号: P00259别名: P21; CIP1; SDI1; WAF1; CAP20; CDKN1; MDA-6; p21CIP1应用: WB,IHC反应种属: Human
-
分类: 科研抗体货号: P00217别名: p94; CANP3; LGMD2; nCL-1; CANPL3; LGMD2A应用: IHC反应种属: Human, Mouse, Rat
-
分类: 科研抗体货号: P00170别名: HB1; Hb-1; KRTHB1; MLN137; ghHkb1; hHAKB2-1应用: WB,IHC反应种属: Human, Mouse
-
分类: 科研抗体货号: P00258别名: TAK, C-2k, CTK1, CDC2L4, PITALRE应用: WB反应种属: Human, Mouse, Rat
-
分类: 科研抗体货号: P00209别名:应用: IHC反应种属: Human, Mouse, Rat

鄂公网安备42018502007531号
鄂公网安备42018502007531号

